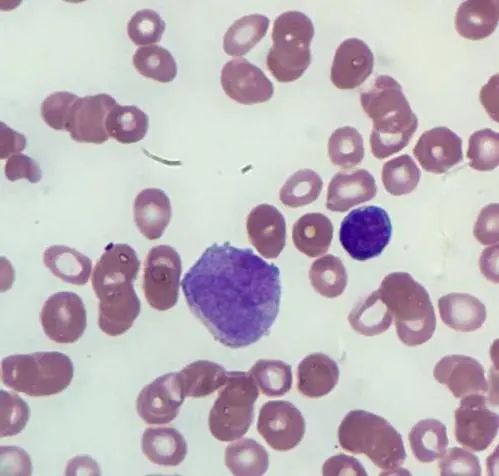

一例罕见M3现形记
急性早幼粒细胞白血病(M3)是急性髓细胞白血病(AML)的一种特殊类型,占儿童髓细胞白血病的10%。M3的临床表现与AML相同,但出血倾向明显,常以严重出血的弥漫性血管内凝血为首发表现。近年来采用全反式维甲酸诱导分化治疗后,预后得到极大改善,超过80%的患儿可以长期存活。

患儿男,10岁,于5天前翻越3米高墙时不慎坠落,双足部着地后坐卧倒地,随后活动时臀部疼痛,伴头痛、头晕,当时无晕厥,无眼前黑朦,无咳嗽,无呕吐、腹痛,无血尿、血便,随即家属将患儿送往XX医院住院治疗。
诊断:
1、右侧耻骨骨折及右侧髂骨内前缘撕脱性骨折;
2、左额部头皮血肿;
3、弥漫性血管内凝血?
住院期间予制动,促进骨折愈合、止痛、输血(冷沉淀4单位)等治疗,复查凝血功能仍未能纠正,故呼叫120出车接回我院,拟“骨盆骨折、凝血功能异常”收住院进一步治疗,起病以来,患儿精神、睡眠可,胃纳差,大小便正常。
外院检查:WBC 6.92×109/L,HGB 72g/L,PLT 43×109/L,NEUT 61.4%,LYMPH 30.5%。凝血5项:APTT 29秒,PT 20.5秒,P-INR 1.68,TT 27.2秒,Fib 0.5g/L,新D-Dimel 84341μg/L。
其它检查:我院颅脑CT提示1、左侧额部头皮血肿,余颅脑CT平扫未见异常。2、鼻咽腺样体肥大,右侧上颌窦外侧壁局部骨质增厚,意义待定。骨盆CT提示1、左侧髂骨内侧骨折,伴左侧髂窝血肿形成;2、右侧耻骨联合粉碎性骨折,伴周围软组织肿胀。
【实验室检查】:
血常规:WBC 7.3×109/L,RBC 2.58×1012/L,HGB 69 g/L,PLT 42×109/L,见图1。

图1 血常规报告
凝血5项结果,见图2:

图2 凝血5项报告
部分生化结果:LDH:3594 U/L↑(120-250);CRP:66.63 mg/L⬆(0-10);FERR:841.73ng/L(20-200)↑
患儿入院后监测血色素、血小板、凝血功能,反复输注大量冷沉淀、血浆、悬浮红细胞,但凝血功能难以纠正,纤维蛋白原反复降低,且入院后血常规均提示未成熟粒细胞绝对值及百分比异常升高,警惕白血病M3型合并纤溶亢进,随后完善血涂片及骨髓穿刺。
*首次外周血涂片镜检见异常早幼粒细胞图3、图4:

图3 外周血瑞氏染色×*10

图4 外周血瑞氏染色×1000
*骨髓涂片见图5、图6:

图5 骨髓瑞氏染色×1000

图6 骨髓MP0染色×1000
骨髓细胞形态结果:骨髓涂片见大量核型不规则、颗粒增多、内外浆明显的异常早幼粒细胞,比例高达89%,MPO染色强阳性,考虑AML-M3形态学骨髓象,必要时结合流式细胞及融合基因检测。
根据骨髓形态学报告,医生及时给患儿用上全反式维甲酸治疗,以下是治疗后外周血细胞形态变化见图7、图8:
图7 治疗后外周血瑞氏染色×1000

图8 治疗后外周血瑞氏染色×1000
7月14日流式细胞结果,符合APL免疫表型,见图9:

图9 流式细胞结果
7月14日5融合基因筛查报告,WT1过表达,PML-RARa融合基因阴性,见图10:


图10 56融合基因筛查报告
7月14日送检染色体核型分析结果47,XY,+21[8]/46,XY[2],见图11:

图11 染色体结果
8月22日流式细胞结果,未见明显免疫表型异常的早幼粒细胞,见图12:

图12 流式细胞结果
8月22日送检骨髓染色体核型分析结果,46,XY[16],见图13:

图13 骨髓染色体结果
治疗后凝血功能分析结果变化见图14:

图14 治疗后凝血分析结果变化

本例患儿骨髓细胞形态学符合M3,流式细胞结果符合急性早幼粒细胞白血病(APL)免疫表型,多次送检白血病中56融合基因筛查,PML-RARa融合基因检测(FISH),PML-RARa融合基因检测(定性),RARa基因重排检测(FISH)均阴性。
7月14日骨髓细胞染色体核型分析可见核型:47,XY,+21[8]/46,XY[2](结果解释:分析10个中期分裂相,可见8个存在21三体,异常比例为80%)。经核对骨髓染色体结果无误,患儿无先天愚形表现。
8月12日外周血染色体核型分析,细胞培养法G显带分析可见核型46,XY,add(15)(p10)。NCCN指南明确当初诊形态怀疑M3时即可上全反式维甲酸,当细胞遗传学和分子生物学检查不支持APL时应该停止维甲酸治疗,而改为按照AML治疗[1]。
本例患儿7月14日开始用维甲酸治疗,通过对7月14日至7月25日的外周血细胞形态和凝血功能进行回顾性分析,维甲酸诱导治疗后出现分化综合征,外周血涂片异常早幼粒细胞比例逐步下降,中晚幼粒细胞、成熟粒细胞比例上升,且细胞形态逐渐往正常方向发展,凝血功能亦在改善。
考虑到该患儿是低保户,经济条件差,父亲60多岁卫生意识不强,按照AML治疗患儿免疫力低容易出现感染。结合外院专家意见,调整为维甲酸和复方黄黛片口服治疗方案。8月27日骨髓缓解,带药出院。通过一年多观察,骨髓复查未见异常。

急性早幼粒细胞白血病(M3)是一种具有特异染色体核型和基因改变的白血病,90%的患者存在典型的t(15,17),而99%的患者可检测到PML-RARa融合基因[2]。
文献报道形态学符合 APL的PML/RARa融合基因阴性的AML临床少见。为一组异质性疾病,多数患者对维甲酸(ATRA)、三氧化二砷(ATO)治疗无效。应结合染色体、基因结果,选择合适药物治疗。
没有条件检测ATRA、ATO敏感基因或这两种药物疗效差时,应尽早应用急性髓系白血病化疗方案诱导治疗,以提高患者缓解率,改善预后[3]。获得性21三体在急性髓系白血病(AML)中发生率较低,常伴随其他的细胞遗传学异常,发生率约为0.9%,而单纯获得性21三体仅为0.3%-0.5%。
APL伴获得性21三体的报道较少,国内陆滢等[4]统计3329例初发AML患者中31例合并获得性21三体,而无一例是M3患者,足可见罕见。
查阅国内个文献并无常规染色体检测提示获得性21三体且无t(15,17)的M3报道[5]。而形态学符合APL的PML/RARa融合基因阴性合并获得性21三体更未见报道。因此发病率低,对该类患者的发病及预后并无大宗的数据统计。
本例患者在治疗初期骨髓染色体47,XY,+21[8]/46,XY[2],治疗期间外周血染色体核型分析结果为46,XY,add(15)(p10),疾病治疗缓解后复查骨髓染色体提示正常核型,表明获得性21三体与M3的发病可能存在一定的关系。本例患儿虽然PML/RARa融合基因阴性合并获得性21三体,庆幸的是维甲酸(ATRA)和复方黄黛片口服治疗有效,可惜未进行NGS检测,要不可能会发现更多RARa基因的伙伴基因。
• 参考文献
编辑:骆秉涵

